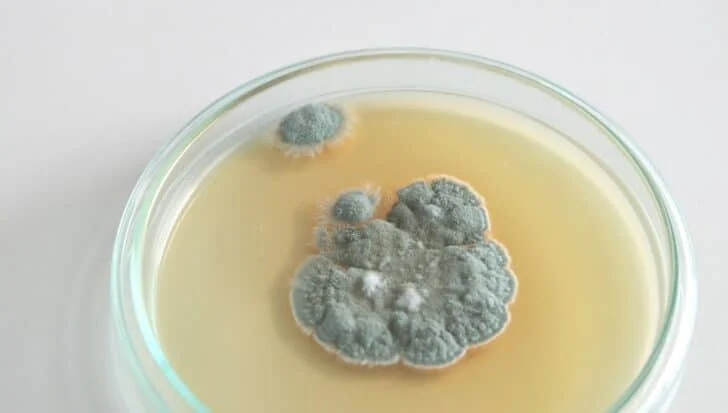
Petri dish with mold indicating the process of discovering penicillin

Chemical reactions occur constantly all around us, even within our own bodies. Over millennia, humanity has learned how to harness some of these chemical reactions to our advantage.
From the discovery of soap to the creation of bronze tools, this modern-day magic has completely transformed entire civilizations.
If you want to learn about the impact of chemistry on the world, keep reading as we explore how seven chemical reactions changed the course of history.
Saponification

Around 2,800 B.C., humanity discovered that by mixing just three simple ingredients—animal fat, wood ash, and water— we could make soap. While simple, this is a chemical reaction, and its name is saponification.
At first, we mainly used soap to clean other materials, such as cotton and wool. However, over time, we realized we could also use it to wash our bodies.
With the discovery of microorganisms, soap became even more prized as a cleaning agent, especially once we realised it could prevent illnesses.
Although soap-making has undergone some modern tweaks, at its core, it remains the same simple reaction we were making all those thousands of years ago.
Synthesized ammonia

Fritz Haber revolutionized the agricultural industry in 1909 by developing a process to extract nitrogen from the air and convert it into ammonia, a usable form of nitrogen.
His colleague Carl Bosch then scaled up the process, making nitrogen fertilizers. But what makes this so important?
Plants need nitrogen to grow, which they typically extract from the soil. However, after repeated harvest cycles, crop productivity drops as nitrogen levels drop.
Nitrogen makes up about 78% of our atmosphere, but plants can’t use it in this form. Some microorganisms can fix nitrogen into the soil, but it’s a slow process.
Historically, different crops were rotated through fields to maintain balanced nutrient levels.
With Haber and Bosch’s process, the Haber-Bosch process, famine was prevented, and we moved a large step closer to industrialised farming.
Then WWI happened and Nazi Germany had plenty of ammonia to to create lots of ammunition, and Haber went on to invent chlorine gas.
The Maillard reaction

You may never have heard of the Maillard reaction, but you use it all the time in your kitchen.
It’s the secret behind the toasty brown crust on freshly baked bread and that devilishly delicious crust on a well-seared steak; it’s the hero in disguise behind crème brûlée.
So, what happens during the Maillard reaction? During cooking, the sugars and proteins in food undergo a chemical reaction from the heat that transforms them into thousands of compounds that give food its flavor and aroma.
Ancient humans discovered that cooked food smelled and tasted better, was easier to digest, and kept them fuller for longer.
Discovery of penicillin
In 1928, Dr. Alexander Fleming walked into his lab after a holiday to find something unusual: A fungus had contaminated a petri dish he was using to grow Staphylococcus bacteria in.
Rather than binning the contaminated specimen, he decided to take a closer look. That singular decision led to an incredible, groundbreaking discovery.
He noticed the bacteria wouldn’t grow near the fungus, so he looked into it further.
The mold, later identified as Penicillium notatum, produced a substance that killed the bacteria by breaking down their cell walls.
Despite Fleming’s best efforts, he couldn’t isolate the active chemical produced by the fungus.
Over a decade later, Dr. Howard Florey, Dr. Ernst Chain, and a team of other scientists at Oxford University successfully created a crude extract from the mold.
Far from perfect, the initial process required 528 gallons (2,000 liters) of mold culture to extract enough penicillin for one severely ill person.
By the 1940s, crops had been established and processes refined. With that, penicillin ushered in the antibiotic era, saving countless lives.
Synthesis of chlorofluorocarbons

Chlorofluorocarbons, also known as Freons or CFCs, were invented in the 1920s by Thomas Midgley Jr.
At the time, refrigerators used highly toxic refrigerants such as ammonia, methyl chloride, and sulfur dioxide.
CFCs, a non-toxic, nonflammable, and stable chemical, seemed like the perfect alternative. Unfortunately, no one knew that CFCs break down under UV light.
By the 1950s, CFCs were everywhere, from refrigerators and air conditioners to aerosols.
The CFCs eventually made it to the upper atmosphere, where they reacted with UV rays from the Sun and released chlorine.
The chlorine gradually ate a hole in the ozone layer, allowing more of the Sun’s harmful rays in. It wasn’t until 1974 that scientists predicted the damage, and it was very nearly too late.
The Montreal Protocol was ultimately signed in 1987 by nearly every country in the world, and, with a few necessary exceptions, led to the effective ban on all CFC production worldwide.
Somehow, it worked: Our planet is gradually recovering its ozone layer.
For the very first time, all UN members unanimously agreed on a treaty, making the phase-out of CFCs a landmark moment in UN history.
Fermentation
![]()
Fermentation is a natural chemical process by which certain living organisms, particularly microbes, break down complex carbohydrates into simpler alcohols, acids, and gases.
This natural process existed long before humans and was almost certainly an accidental invention.
This likely happened as early as 10,000 B.C., when humanity began storing food under primitive conditions.
We eventually mastered this living chemical process, transforming our industries and eventually making all kinds of delicacies like cheese, bread, yogurt, sauerkraut, kimchi, and, of course, alcohol.
Purification of silicon

Silicon can be found all around us in its natural form, but it’s always combined with other elements. For example, most sand is silicon dioxide, a combination of silicon and oxygen.
It wasn’t until 1854 that French chemist Henri Étienne Sainte-Claire Deville isolated crystalline silicon. It might have seemed like a pointless invention at the time, but it became one of the most important materials in the modern world.
What makes silicon so special in today’s world is that it’s a semiconductor, meaning it can conduct electricity while also being heat-resistant.
These qualities make it the perfect material for making microchips and microprocessors for electronic devices.
Since silicon can be found everywhere, it makes technology cheaper and more accessible to everyone.
From fertilizers to microchips, some of the world’s most impactful inventions have come from chemical reactions.
Some were discovered intentionally, some by pure chance, and some, like chlorofluorocarbons, completely backfired.
For good or for worse, that won’t stop us. Humanity will continue exploring the unknown, if for no other reason than it’s a rather fun thing to do.